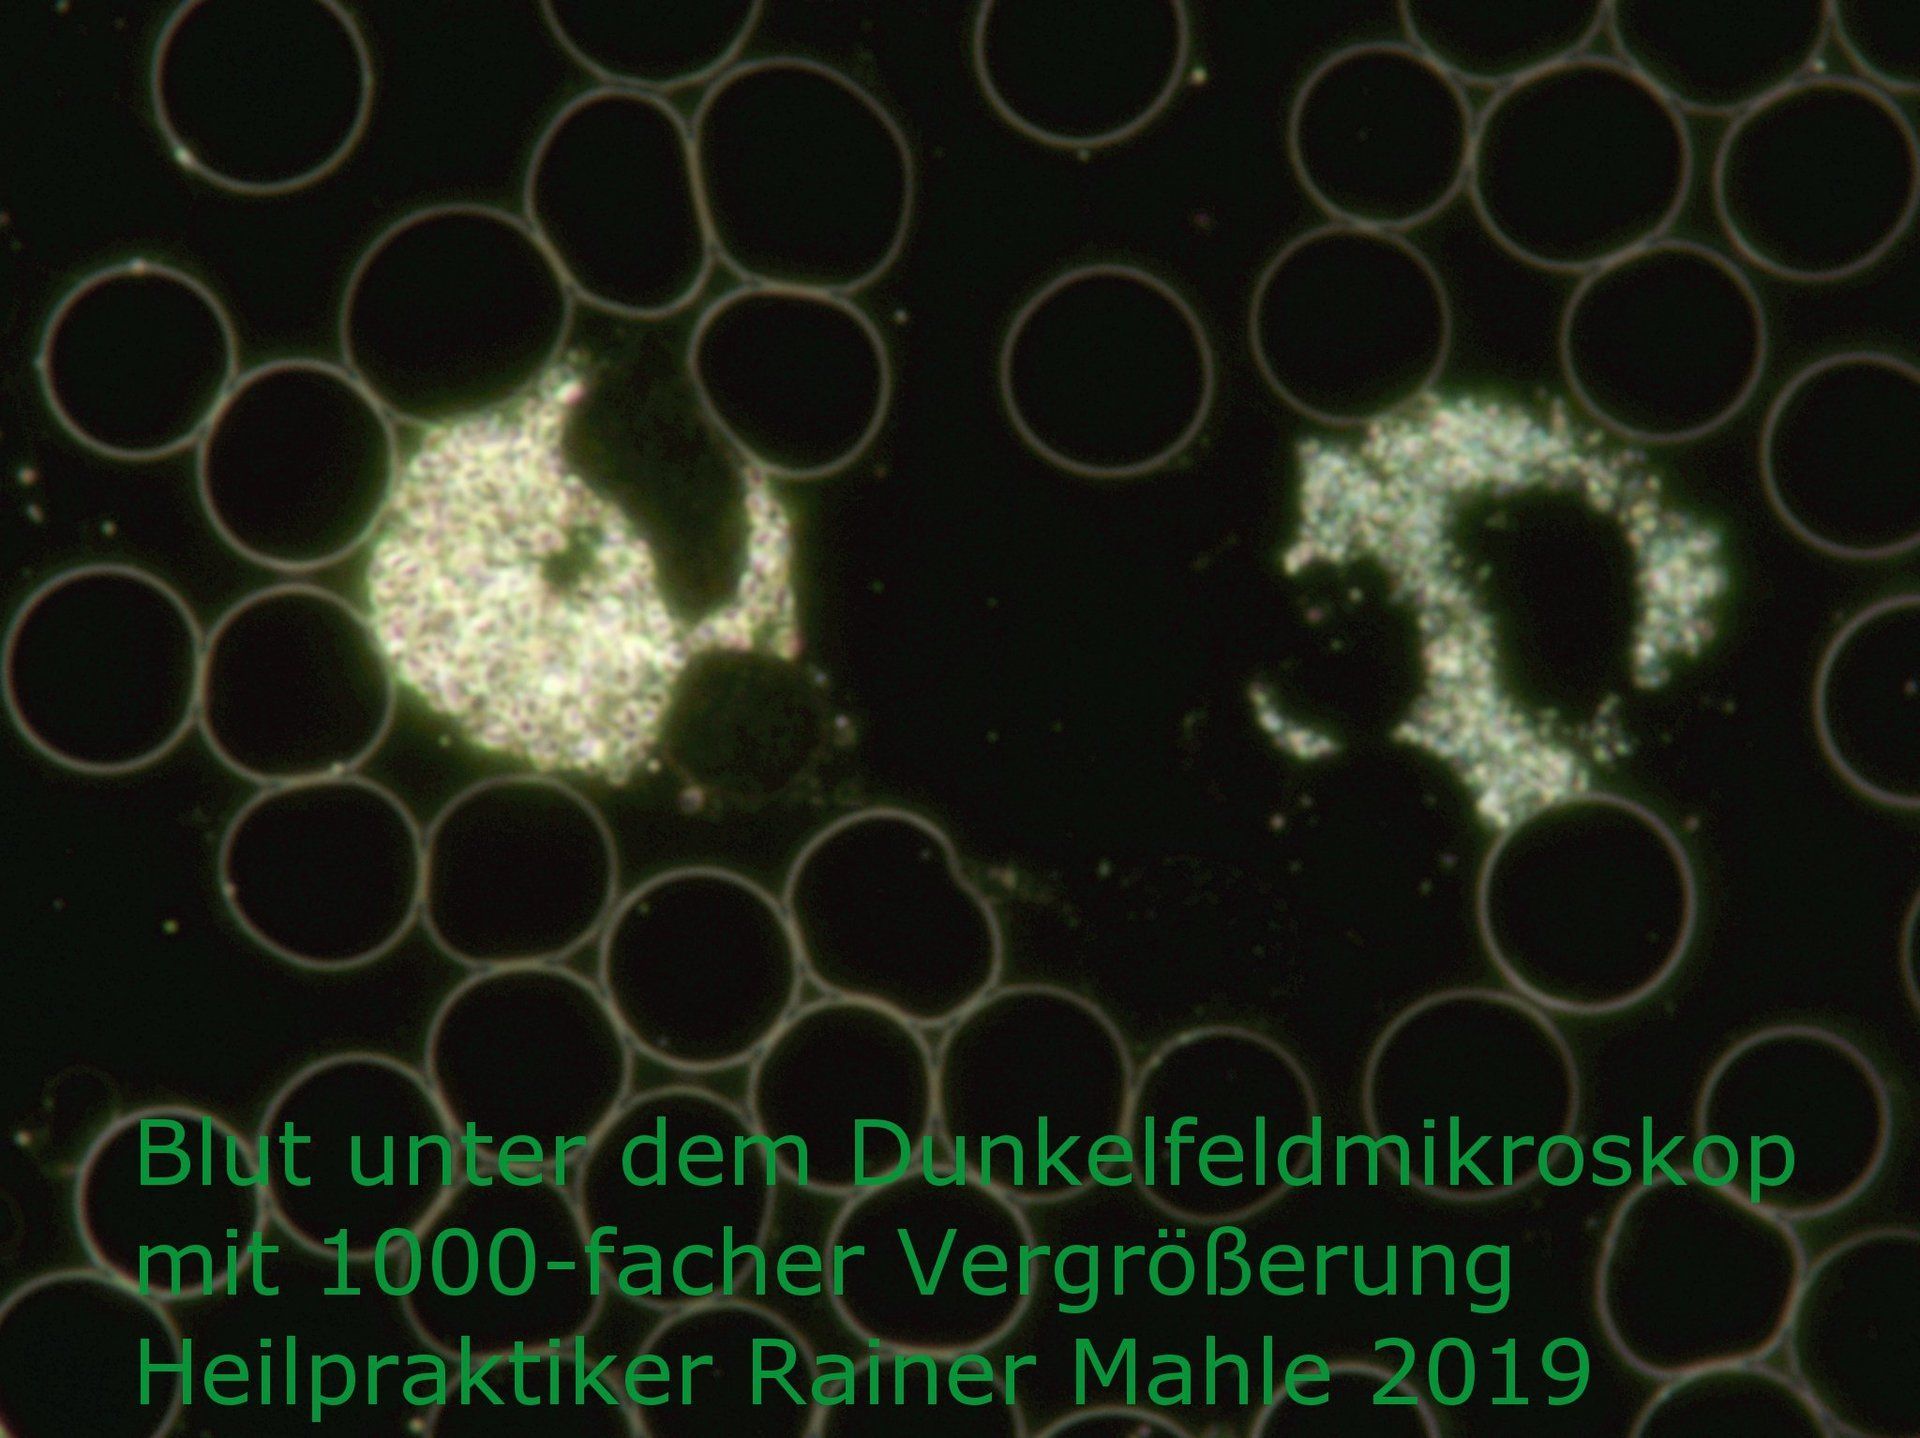
blut unter dem dunkelmikroskop

Praxis

Über meine Praxis
Neben den bekannten Therapieverfahren Chiropraktik und Homöopathie behandle ich Sie auch mit weniger bekannten wie Breußmassage, Dorntherapie, Isopathie und Eigenbluttherapie. Oder sehr alten traditionellen Therapieverfahren wie Schröpfen, Blutegeltherapie und Aderlass. Kolloide und Biophotonenpflaster ergänzen die Behandlungen nach Bedarf.
Welche Therapie für Sie die richtige ist ergründe ich bei einem ausführlichen Erstgespräch. Bei Bedarf besteht die Möglichkeit einer Blutuntersuchung mi einem modernen Dunkelfeldmikroskop.
Auch eine Kombination aus zwei oder mehreren Therapien ist möglich. Viele naturheilkundlichen Therapieformen sind für unseren Körper Hilfe zur Selbsthilfe. Heilung oder Linderung benötigen daher mitunter etwas Zeit.
Alle Behandlungen werden nach dem Gebührenverzeichnis für Heilpraktiker (GebüH) oder individuellem Angebot abgerechnet. Auslagen werden Ihnen zum Gestehungspreis weiter berechnet. Die Behandlungskosten sind unabhängig von einem Behandlungserfolg zu begleichen. Bitte klären Sie im Vorfeld inwieweit ihre Krankenkasse die Kosten übernimmt. Gesetzliche Krankenversicherungen ohne Zusatzversicherungen übernehmen die Kosten i.d.R. nicht.
Naturheilkundliche Vita

Schlüsselerlebnis
Für Themen aus der Naturheilkunde und speziell der Homöopathie war ich immer offen. Eines Tages las ich einen extrem negativen Artikel über Homöopathie. Aus heutiger Sicht war der Artikel sicher falsch, der Homöopathie habe ich aber erst mal abgeschworen.
Viele Jahre später erkrankte mein Kater. Die von der Tierärztin verabreichten Kortisonspritzen wirkten gut, allerdings nur kurz und waren teuer. Jeden Monat mindestens zwei Spritzen konnten auf die Dauer keine Lösung sein.
Die Lösung war dann das homöopathische Konstitutionsmittel. Die Wirkung setzte so plötzlich und eindrücklich ein - es war mir vollkommen unerklärlich. Doch immer wenn die Symptome auftraten konnte nach Mitteleinnahme der selbe augenblicklich positive Effekt erzielt werden. Dieses bis heute Orientierung gebende Schlüsselerlebnis war der Beginn der intensiven Zuwendung zur Homöopathie.
Feuer und Flamme
Einen Placeboeffekt habe ich für mich ausgeschlossen, da mein Kater seine Globuli immer in einem Leckerli versteckt verabreicht bekam. Da musste demnach doch mehr dahinterstecken. Aus meinem ungläubigen Erstaunen erwuchs große Neugier. Diese stillte ich zuerst mit einigen der reichlich angebotenen Bücher. Die Geschichte und Wirkweise der Homöopathie war dort in der Regel gut erklärt. Mit der Findung eines wirksamen Mittels hat es allerdings fast nie geklappt!
Inzwischen Feuer und Flamme für die Homöopathie, belegte ich einen Kurs über Notfall- und Akutmittel. Es folgten ein homöopathischer Repertorisationskurs (Tecknik der Mittelfindung) und eine mehr als zweijährige Ausbildung in Abendkursen zum Thema klassische prozessorientierte Homöopathie.
Während dieser Ausbildung bekam ich auch immer wieder den „Fingerzeig“ doch eine Heilpraktikerausbildung als rechtlich sichere Basis einer Behandlung anzustreben. Das hat aber beruflich, zeitlich und finanziell nicht ins damalige Leben gepasst.
Heilpraktiker-ausbildung
Knapp sechs Jahre später habe ich noch mal Maß genommen. Nach Überprüfung des regionalen Angebotes war klar, beruflich werde ich es unterbringen, zeitlich ist das zu stemmen und finanziell realisierbar.
Ich begann nach einem Schnupperunterricht eine Ausbildung zum Heilpraktiker an der Heilpraktikerschule May in Bad Wörishofen. Entfernung, Ausbildungskonzept und Atmosphäre schien hervorragend zu stimmen. Rund 15 Monate später hat sich das bestätigt und ich hielt meine „Erlaubnis zur Ausübung der Heilkunde ohne Bestallung“ in Händen. Von Bonnie-Sue und Robert auf den Punkt genau top-fit für die Prüfung gemacht, mit grandios einfachen Unterrichtseinheiten und visuell einprägsamen Zusammenfassungen.
Ich war Heilpraktiker.